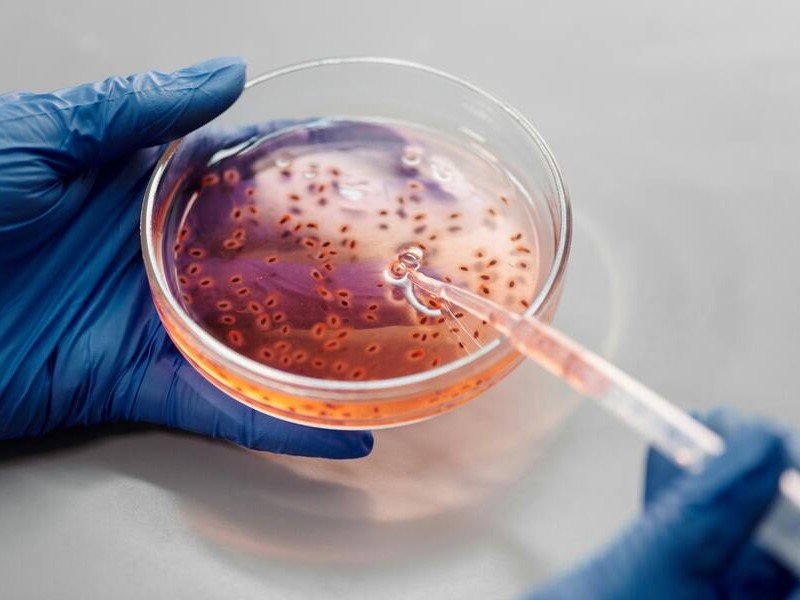

Dirección
Calle Metepec N.13, Entre Cuautepec y Acaxochitlan. Col. Hidalgo Unido. Tulancingo Hgo.
Horarios
Domingo: 11AM y 12:30PM
Miércoles: 7PM
¡EL PECADO!
La consecuencia de esta enfermedad, produce muerte física y espiritual. “Por que la paga del pecado es muerte…” Rom. 6:23
Dios suplió el medio para salvarnos de esa enfermedad:
“Más Dios muestra su amor para con nosotros, en que siendo aún pecadores, Cristo murió por nosotros” Rom. 5:8
¿Qué necesito para ser librado de esta enfermedad?
DEBES ARREPENTIRTE DE TUS PECADOS Y ACEPTAR A JESUS COMO TU SALVADOR, RECUERDA:
TODOS SOMOS PECADORES
“Por cuanto todos pecaron, y están destituidos de la gloria de Dios” (Romanos 3:23). Hemos quebrantado la ley de Dios y somos culpables delante de él. ”Porque la paga del pecado es muerte” (Romanos 6:23). El castigo por nuestro pecado es la muerte, por lo tanto, el pecado nos separa de Dios.
CREE QUE CRISTO MURIÓ POR TI
“Más Dios muestra su amor para con nosotros, en que siendo aún pecadores, Cristo murió por nosotros” (Romanos 5:8). Cristo demostró su amor por nosotros al morir en la cruz y pagar nuestra deuda del pecado.
ARREPIÉNTETE Y RECIBE A CRISTO
“Mas a todos los que le recibieron, a los que creen en su nombre, les dio potestad de ser hechos hijos de Dios” (Juan 1:12). Ahora mismo, si usted sinceramente se arrepiente de sus pecados y quiere ser perdonado…
HAZ UNA ORACIÓN Y PIDE A JESÚS QUE SEA TUSALVADOR:
¡Señor Jesús, reconozco que he pecado, perdóname, me arrepiento y te pido que entres en mi corazón y lo limpies con tu sangre de todo pecado, llévame al cielo cuando yo muera, en el nombre de Jesús, Amén!